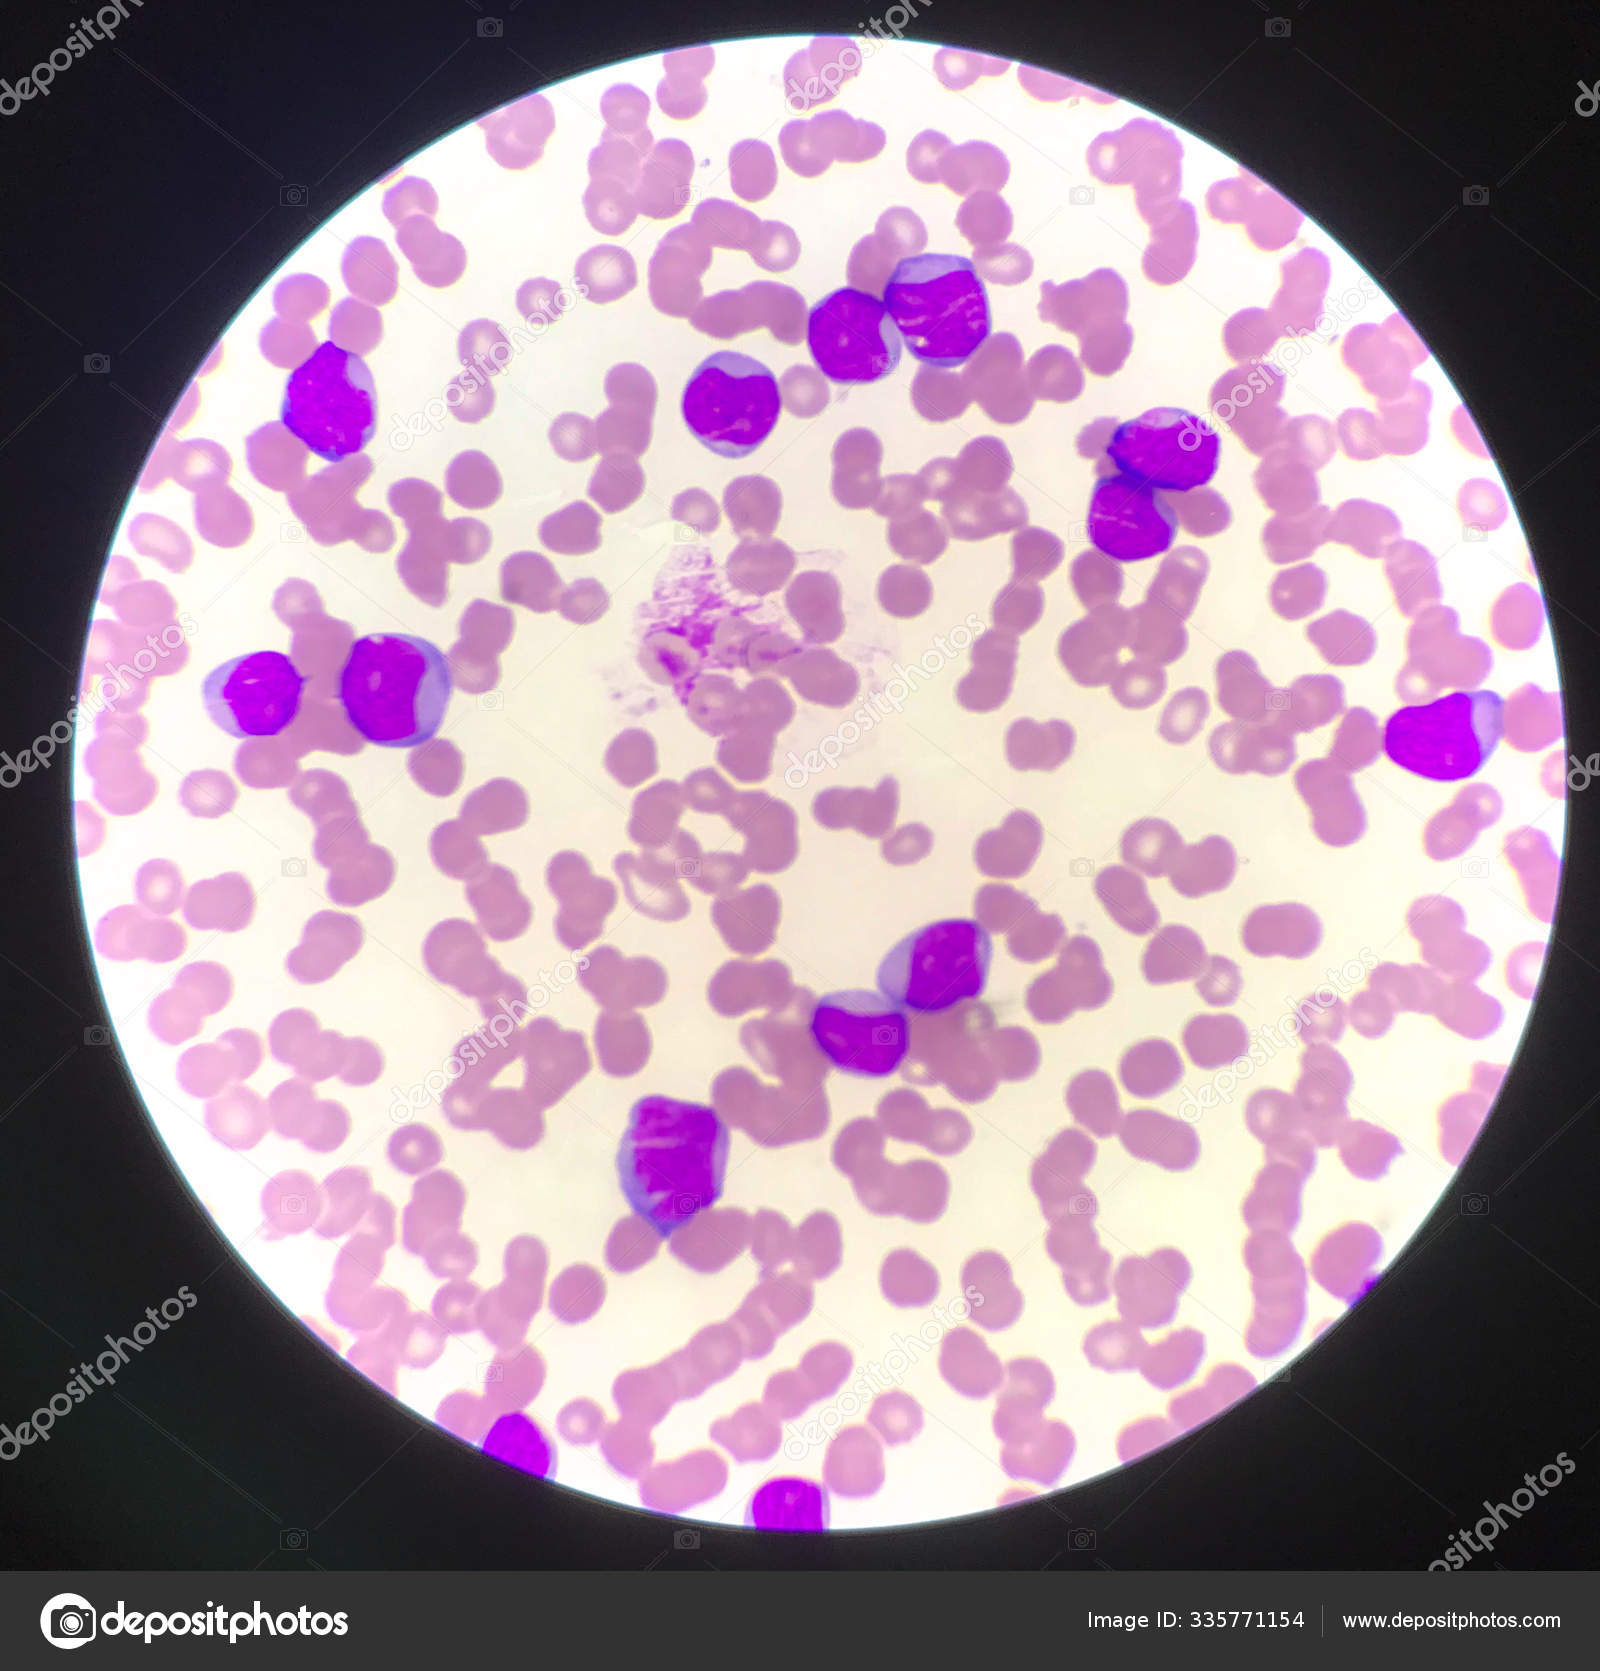

Large immature

ππ»ππ»ππ» FOR MORE INFORMATION, CLICK HERE ππ»ππ»ππ»
Drinking Dog Cum
Call On Me Pornstar Version
Nikki Bella Is Naked
Chubby Amateur Nude Bbw
Outstanding Gauge in library
Cock-gagged and jizzied on her face
Hot Webcam Babe Close Up On Ass And Pussy
Large immature













_Duars_W_Picture_246.jpg">

































%5E_Immature_male_-_Flickr_-_gailhampshire.jpg">